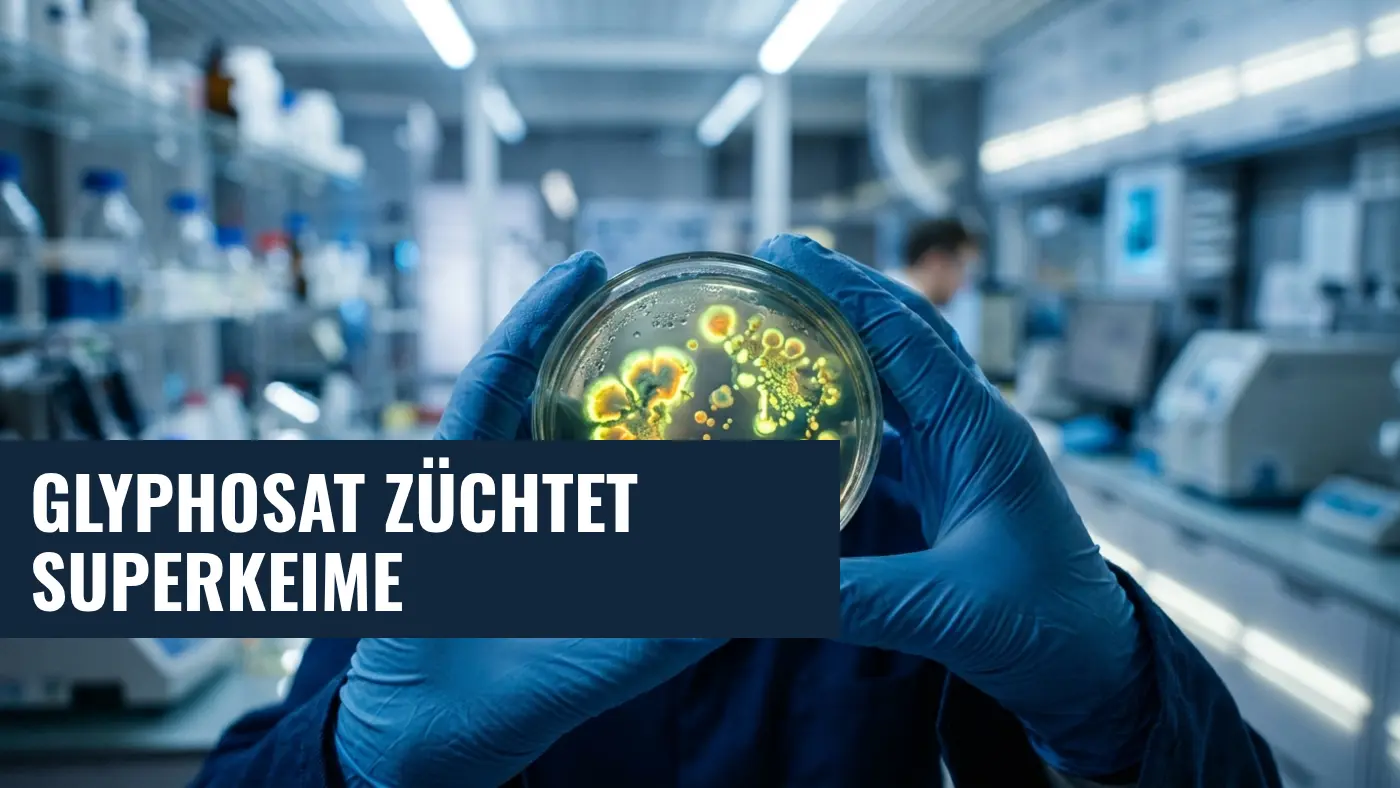
Glyphosat & Antibiotikaresistenz: Studie warnt vor Superkeimen

Gefahr durch Unkrautvernichter: Wie Glyphosat tödliche Krankenhauskeime züchtet
Die zunehmende Unwirksamkeit von Antibiotika gilt als eine der größten globalen Gesundheitsbedrohungen unserer Zeit. Bislang wurde dieses Problem vor allem auf den übermäßigen Einsatz der Medikamente in der Human- und Tiermedizin zurückgeführt. Doch nun rückt ein völlig neuer, unerwarteter Treiber in den Fokus der Wissenschaft: Der weltweit am häufigsten eingesetzte Unkrautvernichter Glyphosat.
Alarmierende Ergebnisse einer neuen Studie
Wie das Deutsche Ärzteblatt unter Berufung auf aktuelle Forschungsergebnisse berichtet, haben Wissenschaftler des Instituts für Medizinische Mikrobiologie und Parasitologie in Buenos Aires herausgefunden, dass der massenhafte Einsatz von Glyphosat in der Landwirtschaft die Entstehung sogenannter "Superbugs" – also multiresistenter Bakterien – massiv begünstigen könnte. Die im renommierten Fachjournal Frontiers in Microbiology veröffentlichte Studie zeigt, dass Bakterien, die gegen das Herbizid resistent werden, häufig als Nebeneffekt eine Immunität gegen lebensrettende Antibiotika entwickeln.
Für die Untersuchung sammelte das Forschungsteam um Dr. Daniela Centrón Dutzende Bakterienstämme aus einem Naturschutzgebiet im argentinischen Paraná-Delta. Obwohl in dem Schutzgebiet selbst kein Glyphosat gesprüht wird, gelangen die Chemikalien aus den umliegenden landwirtschaftlichen Flächen über den Wasserkreislauf dorthin. Die Forscher testeten die Mikroorganismen gegen 16 gängige Antibiotika sowie gegen reines Glyphosat und handelsübliche Herbizide.
Der unsichtbare Weg der Superkeime
Die Resultate sind besorgniserregend: Viele der Umweltbakterien wiesen eine erschreckende Toleranz gegenüber extrem hohen Glyphosatmengen auf. Gleichzeitig verglichen die Wissenschaftler diese Proben mit berüchtigten Krankenhauskeimen, die bereits gegen Reserveantibiotika wie Carbapeneme immun sind. Das alarmierende Ergebnis: Nahezu alle multiresistenten Klinikstämme waren ebenfalls hochgradig resistent gegen Glyphosat.
Die Forscher warnen vor einem fatalen Kreislauf: Wenn resistente Bakterien aus Krankenhäusern – beispielsweise über ungeklärtes Abwasser – in die Umwelt gelangen, finden sie auf landwirtschaftlichen Böden, die mit Glyphosat behandelt wurden, ideale Überlebensbedingungen. Die Äcker könnten sich so in regelrechte Brutstätten für unbehandelbare Superkeime verwandeln, die schließlich über das Grundwasser oder die Nahrungskette wieder zum Menschen zurückkehren.
Was bedeutet das für Krankenhäuser und die Pflege?
Für das Gesundheitswesen, insbesondere für Krankenhäuser und Pflegeeinrichtungen, bergen diese Erkenntnisse eine enorme Sprengkraft. Sogenannte nosokomiale Infektionen (Krankenhausinfektionen) sind für geschwächte Patienten und pflegebedürftige Senioren oft lebensbedrohlich. Weltweit sterben jährlich schätzungsweise über eine Million Menschen an antimikrobiellen Resistenzen. Wenn Umweltgifte wie Glyphosat diese Resistenzen weiter anheizen, könnten selbst einfache Infektionen in Zukunft kaum noch behandelbar sein.
Die wichtigsten Erkenntnisse im Überblick:
- Doppelte Resistenz: Bakterien, die den Kontakt mit Glyphosat überleben, sind oft auch immun gegen wichtige Antibiotika.
- Gefährlicher Austausch: Der Wasserkreislauf verbindet Krankenhäuser und landwirtschaftliche Nutzflächen, wodurch sich die gefährlichen Keime rasant ausbreiten können.
- Klinik-Keime profitieren: Multiresistente Erreger aus Kliniken gedeihen auf glyphosatbelasteten Böden besonders gut und verdrängen harmlose Bakterien.
- Forderung nach Warnhinweisen: Wissenschaftler fordern nun, dass Herbizide künftig Warnhinweise auf die Gefahr der Resistenzbildung tragen müssen.
Die Studie unterstreicht eindrucksvoll den sogenannten "One Health"-Ansatz, der besagt, dass die Gesundheit von Mensch, Tier und Umwelt untrennbar miteinander verbunden ist. Um die Ausbreitung tödlicher Superkeime in Krankenhäusern und Pflegeheimen zu stoppen, reicht es künftig nicht mehr aus, nur den Einsatz von Antibiotika in der Medizin zu drosseln. Auch der weltweite Umgang mit landwirtschaftlichen Chemikalien muss dringend auf den Prüfstand gestellt werden.
Brauchen Sie Unterstützung bei der Pflege?
PflegeHelfer24 ist Ihr verlässlicher Partner. Entdecken Sie unsere Ratgeber oder lassen Sie sich kostenlos zu Pflegehilfsmitteln, Treppenliften und Zuschüssen beraten.






















